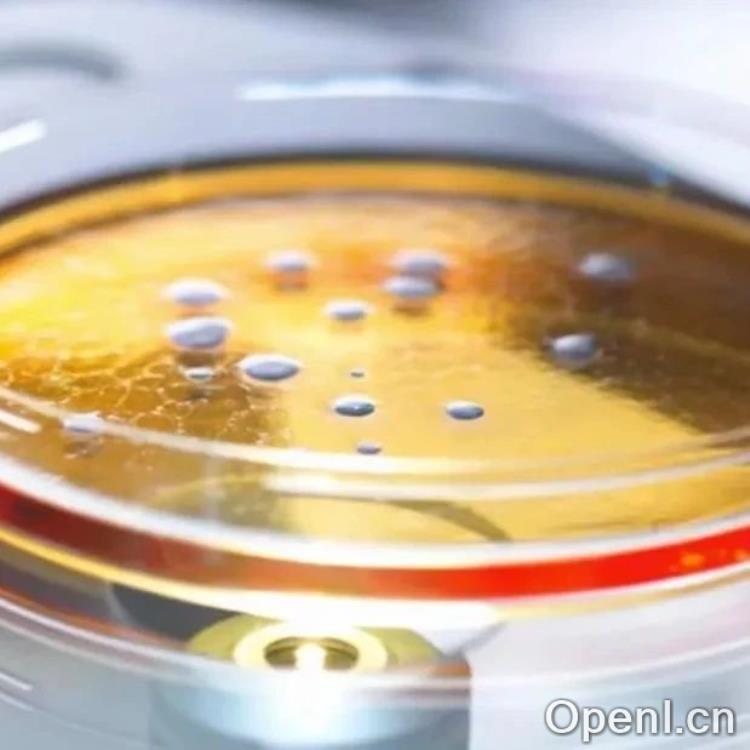
Science：呼吁全球禁止镜像生命的研究

原标题:Science:呼吁全球禁止镜像生命的研究
文章来源:人工智能学家
内容字数:11989字
镜像生命:潘多拉魔盒还是医学突破?
近日,一个由诺贝尔奖获得者领衔的国际专家小组在《Science》杂志上发表文章,警告称对“镜像生命”的研究可能带来前所未有的风险。文章引发了关于镜像生命研究伦理和安全性的广泛讨论。
1. 镜像生命是什么?
地球上所有已知生命体的DNA和RNA由右旋核苷酸构成,蛋白质由左旋氨基酸构成。镜像生命则反之,使用左旋核苷酸和右旋氨基酸构建。虽然科学家已合成大型镜像分子,但构建完整的镜像生物体仍面临技术挑战。然而,一些研究已在构建镜像微生物方面取得初步进展。
2. 镜像生命研究的历史
对镜像生命的探索可以追溯到路易斯·巴斯德时代。科幻小说中也多次出现镜像生命或镜像人的概念,展现了人们对这一未知领域的想象。近年来,合成生物学的快速发展,特别是人工智能在蛋白质和DNA合成中的应用,使得创造镜像生命的可能性大大提高,也进一步加剧了对其潜在风险的担忧。
3. 支持镜像生命研究的观点
支持者认为,镜像细胞可能具有巨大的医学应用价值。镜像蛋白比天然蛋白更具稳定性,这可能成为治疗慢性病的突破。他们主张,对镜像分子(如镜像核酸和蛋白质)的化学合成研究不应受到限制,因为其对基础科学具有重要价值。
4. 反对镜像生命研究的观点
反对者则认为,镜像生物与自然细胞的相互作用不可预测,可能引发无法控制的致命感染,威胁人类、动物和植物的生命安全。他们担心,镜像细菌可能绕过免疫系统,传播无法治愈的流行病。现有抗生素可能对其无效,其潜在的生态风险也难以评估。因此,除非有确凿证据证明镜像生命安全无虞,否则不应进行以创造镜像细菌为目标的研究。
5. 如何规范镜像生命的研究?
专家们呼吁开展国际合作,深入研究镜像生物分子与免疫系统的相互作用,开发检测和防控方法。同时,建议对相关技术进行严格管理,以确保任何试图创造镜像细菌的研究都面临多重科学挑战和限制。 这需要在开放的国际环境中进行,并平衡潜在的益处和风险。
总而言之,镜像生命研究是一把剑,其潜在的医学应用前景令人兴奋,但其巨大的风险也令人担忧。如何在科学探索和生物安全之间取得平衡,是摆在科学家和决策者面前的重大挑战。需要全球范围内的合作与对话,制定严格的伦理规范和安全措施,以确保这项研究能够造福人类,而不是带来灾难。
联系作者
文章来源:人工智能学家
作者微信:
作者简介:致力成为权威的人工智能科技媒体和前沿科技研究机构


粤公网安备 44011502001135号